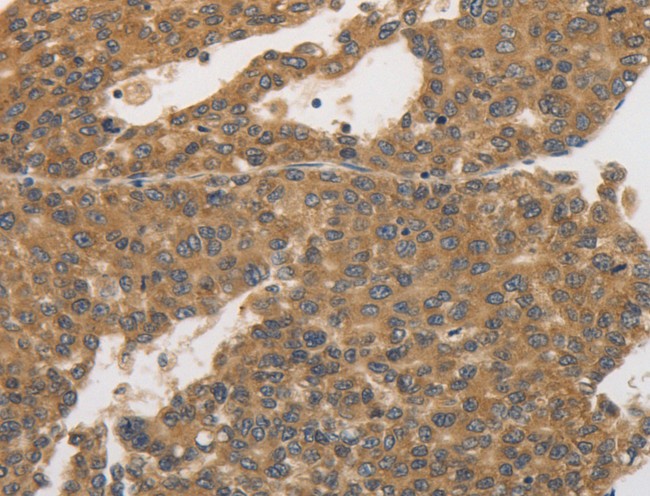
product-image-AAA168387_IHC13.jpg

Rabbit PKD1/PKC mu Polyclonal Antibody | anti-PRKD1 antibody
PKD1/PKC mu Antibody
Phosphate buffered saline, pH 7.4, 150mM NaCl, 0.02% sodium azide and 50% glycerol.
WB (Western Blot)
(Western blot analysis of PKD1/PKC mu expression in HepG2 whole cell lysates, The lane on the left is treated with the antigen-specific peptide.)
IHC (Immunohiostchemistry)
(AF643 at 1/200 staining Human Brian tissue sections by IHC-P. The tissue was formaldehyde fixed and a heat mediated antigen retrieval step in citrate buffer was performed. The tissue was then blocked and incubated with the antibody for 1.5 hours at 22 degree C. An HRP conjugated goat anti-rabbit antibody was used as the secondary.)
IF (Immunofluorescence)
(AAA322422 staining A431 cells by IF/ICC. The sample were fixed with PFA and permeabilized in 0.1% Triton X-100, then blocked in 10% serum for 45 minutes at 25 degree C. The primary antibody was diluted at 1/200 and incubated with the sample for 1 hour at 37 degree C. An Alexa Fluor 594 conjugated goat anti-rabbit IgG (H+L) antibody, diluted at 1/600, was used as secondary antibody.)
Function: Serine/threonine-protein kinase that converts transient diacylglycerol (DAG) signals into prolonged physiological effects downstream of PKC, and is involved in the regulation of MAPK8/JNK1 and Ras signaling, Golgi membrane integrity and trafficking, cell survival through NF-kappa-B activation, cell migration, cell differentiation by mediating HDAC7 nuclear export, cell proliferation via MAPK1/3 (ERK1/2) signaling, and plays a role in cardiac hypertrophy, VEGFA-induced angiogenesis, genotoxic-induced apoptosis and flagellin-stimulated inflammatory response. Phosphorylates the epidermal growth factor receptor (EGFR) on dual threonine residues, which leads to the suppression of epidermal growth factor (EGF)-induced MAPK8/JNK1 activation and subsequent JUN phosphorylation. Phosphorylates RIN1, inducing RIN1 binding to 14-3-3 proteins YWHAB, YWHAE and YWHAZ and increased competition with RAF1 for binding to GTP-bound form of Ras proteins (NRAS, HRAS and KRAS). Acts downstream of the heterotrimeric G-protein beta/gamma-subunit complex to maintain the structural integrity of the Golgi membranes, and is required for protein transport along the secretory pathway. In the trans-Golgi network (TGN), regulates the fission of transport vesicles that are on their way to the plasma membrane. May act by activating the lipid kinase phosphatidylinositol 4-kinase beta (PI4KB) at the TGN for the local synthesis of phosphorylated inositol lipids, which induces a sequential production of DAG, phosphatidic acid (PA) and lyso-PA (LPA) that are necessary for membrane fission and generation of specific transport carriers to the cell surface. Under oxidative stress, is phosphorylated at Tyr-463 via SRC-ABL1 and contributes to cell survival by activating IKK complex and subsequent nuclear translocation and activation of NFKB1. Involved in cell migration by regulating integrin alpha-5/beta-3 recycling and promoting its recruitment in newly forming focal adhesion. In osteoblast differentiation, mediates the bone morphogenetic protein 2 (BMP2)-induced nuclear export of HDAC7, which results in the inhibition of HDAC7 transcriptional repression of RUNX2. In neurons, plays an important role in neuronal polarity by regulating the biogenesis of TGN-derived dendritic vesicles, and is involved in the maintenance of dendritic arborization and Golgi structure in hippocampal cells. May potentiate mitogenesis induced by the neuropeptide bombesin or vasopressin by mediating an increase in the duration of MAPK1/3 (ERK1/2) signaling, which leads to accumulation of immediate-early gene products including FOS that stimulate cell cycle progression. Plays an important role in the proliferative response induced by low calcium in keratinocytes, through sustained activation of MAPK1/3 (ERK1/2) pathway. Downstream of novel PKC signaling, plays a role in cardiac hypertrophy by phosphorylating HDAC5, which in turn triggers XPO1/CRM1-dependent nuclear export of HDAC5, MEF2A transcriptional activation and induction of downstream target genes that promote myocyte hypertrophy and pathological cardiac remodeling. Mediates cardiac troponin I (TNNI3) phosphorylation at the PKA sites, which results in reduced myofilament calcium sensitivity, and accelerated crossbridge cycling kinetics. The PRKD1-HDAC5 pathway is also involved in angiogenesis by mediating VEGFA-induced specific subset of gene expression, cell migration, and tube formation. In response to VEGFA, is necessary and required for HDAC7 phosphorylation which induces HDAC7 nuclear export and endothelial cell proliferation and migration. During apoptosis induced by cytarabine and other genotoxic agents, PRKD1 is cleaved by caspase-3 at Asp-378, resulting in activation of its kinase function and increased sensitivity of cells to the cytotoxic effects of genotoxic agents. In epithelial cells, is required for transducing flagellin-stimulated inflammatory responses by binding and phosphorylating TLR5, which contributes to MAPK14/p38 activation and production of inflammatory cytokines. May play a role in inflammatory response by mediating activation of NF-kappa-B. May be involved in pain transmission by directly modulating TRPV1 receptor. Plays a role in activated KRAS-mediated stabilization of ZNF304 in colorectal cancer (CRC) cells (PubMed:24623306). Regulates nuclear translocation of transcription factor TFEB in macrophages upon live S.enterica infection (By similarity).
Subunit Structure: Interacts (via N-terminus) with ADAP1/CENTA1 (PubMed:12893243). Interacts with MAPK13 (PubMed:19135240). Interacts with DAPK1 in an oxidative stress-regulated manner (PubMed:17703233). Interacts with USP28; the interaction induces phosphorylation of USP28 and activated KRAS-mediated stabilization of ZNF304 (PubMed:24623306). Interacts with AKAP13 (via C-terminal domain) (By similarity).
Post-translational Modifications: Phosphorylated at Ser-397 and Ser-401 by MAPK13 during regulation of insulin secretion in pancreatic beta cells (PubMed:19135240). Phosphorylated by DAPK1 (PubMed:17703233). Phosphorylated at Tyr-95 and by ABL at Tyr-463, which primes the kinase in response to oxidative stress, and promotes a second step activating phosphorylation at Ser-738/Ser-742 by PKRD (PubMed:12637538, PubMed:15024053, PubMed:17804414). Phosphorylated on Ser-910 upon S.enterica infection in macrophages (By similarity).
Similarity: Belongs to the protein kinase superfamily. CAMK Ser/Thr protein kinase family. PKD subfamily.
NCBI and Uniprot Product Information
Predicted: 102 kDa
Customer Reviews
Loading reviews...
Share Your Experience
Similar Products
Product Notes
The PRKD1 prkd1 (Catalog #AAA322422) is an Antibody produced from Rabbit and is intended for research purposes only. The product is available for immediate purchase. The PKD1/PKC mu Antibody reacts with Human, Mouse, Rat and may cross-react with other species as described in the data sheet. AAA Biotech's PKD1/PKC mu can be used in a range of immunoassay formats including, but not limited to, ELISA, ICC (Immunocytochemistry), IF (Immunofluorescence), IHC (Immunohistochemistry), WB (Western Blot). Researchers should empirically determine the suitability of the PRKD1 prkd1 for an application not listed in the data sheet. Researchers commonly develop new applications and it is an integral, important part of the investigative research process. It is sometimes possible for the material contained within the vial of "PKD1/PKC mu, Polyclonal Antibody" to become dispersed throughout the inside of the vial, particularly around the seal of said vial, during shipment and storage. We always suggest centrifuging these vials to consolidate all of the liquid away from the lid and to the bottom of the vial prior to opening. Please be advised that certain products may require dry ice for shipping and that, if this is the case, an additional dry ice fee may also be required.Precautions
All products in the AAA Biotech catalog are strictly for research-use only, and are absolutely not suitable for use in any sort of medical, therapeutic, prophylactic, in-vivo, or diagnostic capacity. By purchasing a product from AAA Biotech, you are explicitly certifying that said products will be properly tested and used in line with industry standard. AAA Biotech and its authorized distribution partners reserve the right to refuse to fulfill any order if we have any indication that a purchaser may be intending to use a product outside of our accepted criteria.Disclaimer
Though we do strive to guarantee the information represented in this datasheet, AAA Biotech cannot be held responsible for any oversights or imprecisions. AAA Biotech reserves the right to adjust any aspect of this datasheet at any time and without notice. It is the responsibility of the customer to inform AAA Biotech of any product performance issues observed or experienced within 30 days of receipt of said product. To see additional details on this or any of our other policies, please see our Terms & Conditions page.Item has been added to Shopping Cart
If you are ready to order, navigate to Shopping Cart and get ready to checkout.